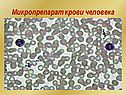

Постоянство внутренней среды организма |
|
Биология 8 класс
Скачать презентацию |
||
| << «Внутренняя среда организма» 8 класс | Иммунная система человека >> |
Скачать презентацию
Биология 8 класс
краткое содержание других презентаций«Гормоны в обмене веществ» - Тимус. Половые железы. Эпифиз. Гормон тироксин. Паращитовидная железа. Недостаток и избыток гормонов. Гормон инсулин. Вилочковая железа. Цель урока. Поджелудочная железа. Надпочечники. Жалобы пациента. Роль гормонов в обмене веществ. Гипофиз. Назовите биологически активные вещества. Гормон кортизон. Функции. щитовидная железа положение в организме. Повторение. Распределите перечисленные железы по группам.
«Темы по биологии 8 класс» - Образование крови: кровь образуется в костном мозге. Возникшие нервные импульсы проводятся в головной мозг. Клетки крови. Полости предверия. Венозная и артериальная кровь. Орган слуха. Лимфотические сосуды. Кости скелета. Внутреннее ухо представляет систему тонких изогнутых каналов. Кровь – это промежуточная внутренняя среда организма. На волоконцах расположенны клетки с волосками. Орган равновесия.
«Значение леса» - Рост числа заболеваний и смертности в Москве. Задымление городов. Охрана лесов. Причины. Правовая охрана лесов. Охрана лесов от пожаров. Значение леса для жизнедеятельности человека. Значение леса в природе. Общая обстановка в России на июнь-август 2010 года. Роль леса в природе и жизни человека. Московский регион. Хронология в Московском регионе. Тушение лесного пожара в Орехово-Зуевском районе 6 августа 2010 года.
«Дождевые черви - животные» - Пищеварительная система. Поперечный разрез. Кровеносная система. Значение. Вторичная полость тела. Класс Малощетинковые черви. Представитель малощетинковых. Нервная система. Общая характеристика типа. Класс Многощетинковые. Выделительная система. Строение головной части. Кожно-мускульный мешок. Размножение. Класс Пиявки. Тип Кольчатые черви. Многообразие кольчатых червей.
«Строение спинного мозга» - Верные суждения. Работа с тетрадью. Заполни таблицу. Строение спинного мозга. Спинной мозг. Сокращения скелетной мускулатуры. Оболочки мозга. Работа в тетради. Особенности строения спинного мозга. Рассмотрите рисунок. Работа над понятиями. Что находится в задних рогах спинного мозга. Схема строения нервной системы. Спинномозговой канал. Какие две основные функции выполняет спинной мозг.
«Сон человека» - Долгоспящие. Суточные. После глубокого сна. Альберт Эйнштейн каждую ночь проводил в постели 10-12 часов. Черчиль работал до 3-4ч ночи, а в 8ч уже снова был на ногах. Биологические ритмы. Около 12% зрячих людей видят только черно-белые сны. Интересные факты о снах и сновидениях. Взрослому человеку достаточно 8-часового сна. Державин во сне сочинил последнюю строфу оды «Бог». Младенец спит 20 часов в сутки.
Всего в теме «Биология 8 класс» 98 презентаций